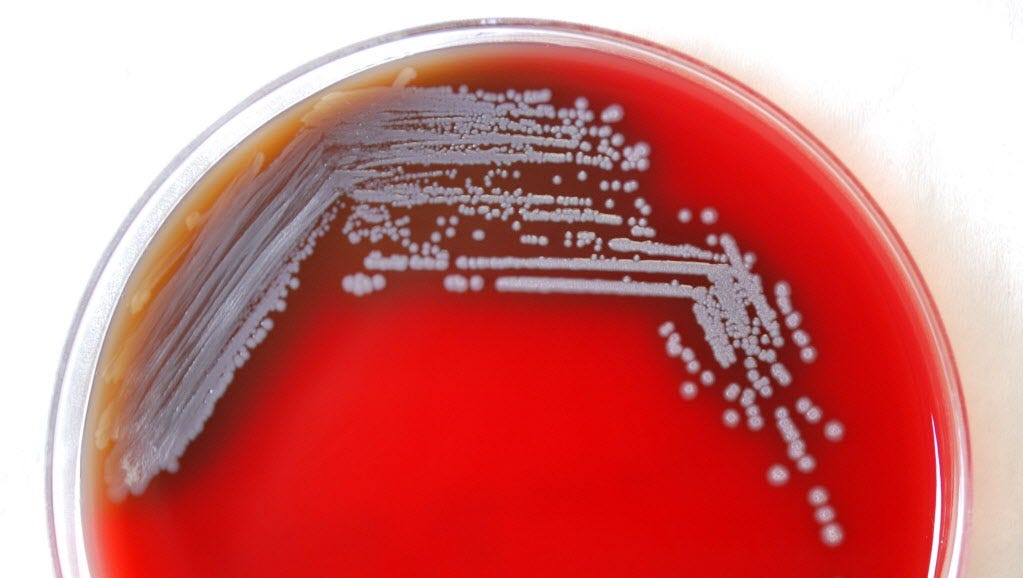

39 tropical freshwater fish crossword clue
Tropical freshwater fish; a popular aquarium fish - crossword puzzle ... Today's crossword puzzle clue is a general knowledge one: Tropical freshwater fish; a popular aquarium fish. We will try to find the right answer to this particular crossword clue. Here are the possible solutions for "Tropical freshwater fish; a popular aquarium fish" clue. It was last seen in British general knowledge crossword. Tropical, Freshwater Fish - Crossword Clue Answers - Crossword Solver The crossword clue Tropical, freshwater fish with 5 letters was last seen on the January 01, 1991. We think the likely answer to this clue is TETRA. Below are all possible answers to this clue ordered by its rank. You can easily improve your search by specifying the number of letters in the answer.
A small, tropical freshwater fish that is typically brightly coloured We will try to find the right answer to this particular crossword clue. Here are the possible solutions for "A small, tropical freshwater fish that is typically brightly coloured" clue. It was last seen in British general knowledge crossword. We have 1 possible answer in our database. Sponsored Links Possible answer: T E T R A

Tropical freshwater fish crossword clue
a brightly coloured tropical freshwater fish (5) Crossword Clue - Wordplays The Crossword Solver found 30 answers to "a brightly coloured tropical freshwater fish (5)", 5 letters crossword clue. The Crossword Solver finds answers to classic crosswords and cryptic crossword puzzles. Enter the length or pattern for better results. Click the answer to find similar crossword clues . Enter a Crossword Clue Sort by Length A small, tropical freshwater fish that is typically brightly coloured ... The Crossword Solver found 30 answers to "A small, tropical freshwater fish that is typically brightly coloured (5)", 5 letters crossword clue. The Crossword Solver finds answers to classic crosswords and cryptic crossword puzzles. Enter the length or pattern for better results. Click the answer to find similar crossword clues . Freshwater fish - crossword puzzle clues & answers - Dan Word Today's crossword puzzle clue is a general knowledge one: Freshwater fish. We will try to find the right answer to this particular crossword clue. Here are the possible solutions for "Freshwater fish" clue. It was last seen in The Daily Telegraph general knowledge crossword. We have 20 possible answers in our database.
Tropical freshwater fish crossword clue. TROPICAL FRESHWATER FISH - 5 Letters - Crossword Solver Help What is the answer to the crossword clue „Tropical freshwater fish" . After exploring the clues, we have identified 1 potential solutions. Clue. length. Answer. Tropical freshwater fish. 5. tetra. Refine the search results by specifying the number of letters. Tropical freshwater fish - Crossword clues & answers - Global Clue Tropical freshwater fish. Let's find possible answers to "Tropical freshwater fish" crossword clue. First of all, we will look for a few extra hints for this entry: Tropical freshwater fish. Finally, we will solve this crossword puzzle clue and get the correct word. We have 1 possible solution for this clue in our database. Tropical freshwater fish - crossword puzzle clues & answers - Dan Word Today's crossword puzzle clue is a quick one: Tropical freshwater fish. We will try to find the right answer to this particular crossword clue. Here are the possible solutions for "Tropical freshwater fish" clue. It was last seen in British quick crossword. We have 1 possible answer in our database. Sponsored Links Possible answer: T E T R A A Brightly Coloured Tropical Freshwater Fish Crossword Clue The crossword clue A brightly coloured tropical freshwater fish with 5 letters was last seen on the August 12, 2018. We think the likely answer to this clue is TETRA . Below are all possible answers to this clue ordered by its rank.
Tropical freshwater fish Crossword Clue | Wordplays.com Tropical freshwater fish Crossword Clue The Crossword Solver found 30 answers to "Tropical freshwater fish", 5 letters crossword clue. The Crossword Solver finds answers to classic crosswords and cryptic crossword puzzles. Enter the length or pattern for better results. Click the answer to find similar crossword clues . Enter a Crossword Clue Tropical, freshwater fish - crossword puzzle clue Clue: Tropical, freshwater fish Tropical, freshwater fish is a crossword puzzle clue that we have spotted 1 time. There are related clues (shown below). Referring crossword puzzle answers TETRA Likely related crossword puzzle clues Sort A-Z Fish Numerical prefix Aquarium fish Colorful fish Freshwater fish Colorful aquarium fish Aquarium favorite tropical freshwater fish 5 Crossword Clue | Wordplays.com tropical freshwater fish 5 Crossword Clue The Crossword Solver found 30 answers to "tropical freshwater fish 5", 5 letters crossword clue. The Crossword Solver finds answers to classic crosswords and cryptic crossword puzzles. Enter the length or pattern for better results. Click the answer to find similar crossword clues . Enter a Crossword Clue Popular Freshwater Aquarium Fish Crossword Clue Popular Freshwater Aquarium Fish Crossword Clue The crossword clue Freshwater fish. with 5 letters was last seen on the April 10, 2023. We found 20 possible solutions for this clue. Below are all possible answers to this clue ordered by its rank. You can easily improve your search by specifying the number of letters in the answer.
Tropical freshwater fish - 1 answer | Crossword Clues Tropical freshwater fish (Crossword clue) We found one answer for "Tropical freshwater fish" . 5 letters TETRA More crossword answers We found one answer for the crossword clue Tropical freshwater fish . Are you looking for more answers, or do you have a question for other crossword enthusiasts? tropical fish Crossword Clue | Wordplays.com tropical fish Crossword Clue The Crossword Solver found 30 answers to "tropical fish", 10 letters crossword clue. The Crossword Solver finds answers to classic crosswords and cryptic crossword puzzles. Enter the length or pattern for better results. Click the answer to find similar crossword clues . Enter a Crossword Clue Sort by Length TROPICAL FRESHWATER FISH Crossword Clue - The Crossword Solver TROPICAL FRESHWATER FISH Crossword Clue 'TROPICAL FRESHWATER FISH' is a 22 letter Phrase starting with T and ending with H All Solutions for TROPICAL FRESHWATER FISH Thanks for visiting The Crossword Solver "TROPICAL freshwater fish". We've listed any clues from our database that match your search for "TROPICAL freshwater fish". Small tropical freshwater fish (5) Crossword Clue - Wordplays Small tropical freshwater fish (5) Crossword Clue The Crossword Solver found 20 answers to "Small tropical freshwater fish (5)", 5 letters crossword clue. The Crossword Solver finds answers to classic crosswords and cryptic crossword puzzles. Enter the length or pattern for better results. Click the answer to find similar crossword clues .
Tropical freshwater fish (5) Crossword Clue | Wordplays.com The Crossword Solver found 30 answers to "Tropical freshwater fish (5)", 5 letters crossword clue. The Crossword Solver finds answers to classic crosswords and cryptic crossword puzzles. Enter the length or pattern for better results. Click the answer to find similar crossword clues . Enter a Crossword Clue Sort by Length # of Letters or Pattern
Brightly coloured tropical freshwater fish with neon and cardinal ... Today's crossword puzzle clue is a general knowledge one: Brightly coloured tropical freshwater fish with neon and cardinal varieties. We will try to find the right answer to this particular crossword clue. Here are the possible solutions for "Brightly coloured tropical freshwater fish with neon and cardinal varieties" clue.
Freshwater fish - crossword puzzle clues & answers - Dan Word Today's crossword puzzle clue is a general knowledge one: Freshwater fish. We will try to find the right answer to this particular crossword clue. Here are the possible solutions for "Freshwater fish" clue. It was last seen in The Daily Telegraph general knowledge crossword. We have 20 possible answers in our database.
A small, tropical freshwater fish that is typically brightly coloured ... The Crossword Solver found 30 answers to "A small, tropical freshwater fish that is typically brightly coloured (5)", 5 letters crossword clue. The Crossword Solver finds answers to classic crosswords and cryptic crossword puzzles. Enter the length or pattern for better results. Click the answer to find similar crossword clues .
a brightly coloured tropical freshwater fish (5) Crossword Clue - Wordplays The Crossword Solver found 30 answers to "a brightly coloured tropical freshwater fish (5)", 5 letters crossword clue. The Crossword Solver finds answers to classic crosswords and cryptic crossword puzzles. Enter the length or pattern for better results. Click the answer to find similar crossword clues . Enter a Crossword Clue Sort by Length

:strip_icc()/red-bellied-piranha-692340088-5c2ce4dac9e77c0001cdaf27.jpg)


0 Response to "39 tropical freshwater fish crossword clue"
Post a Comment